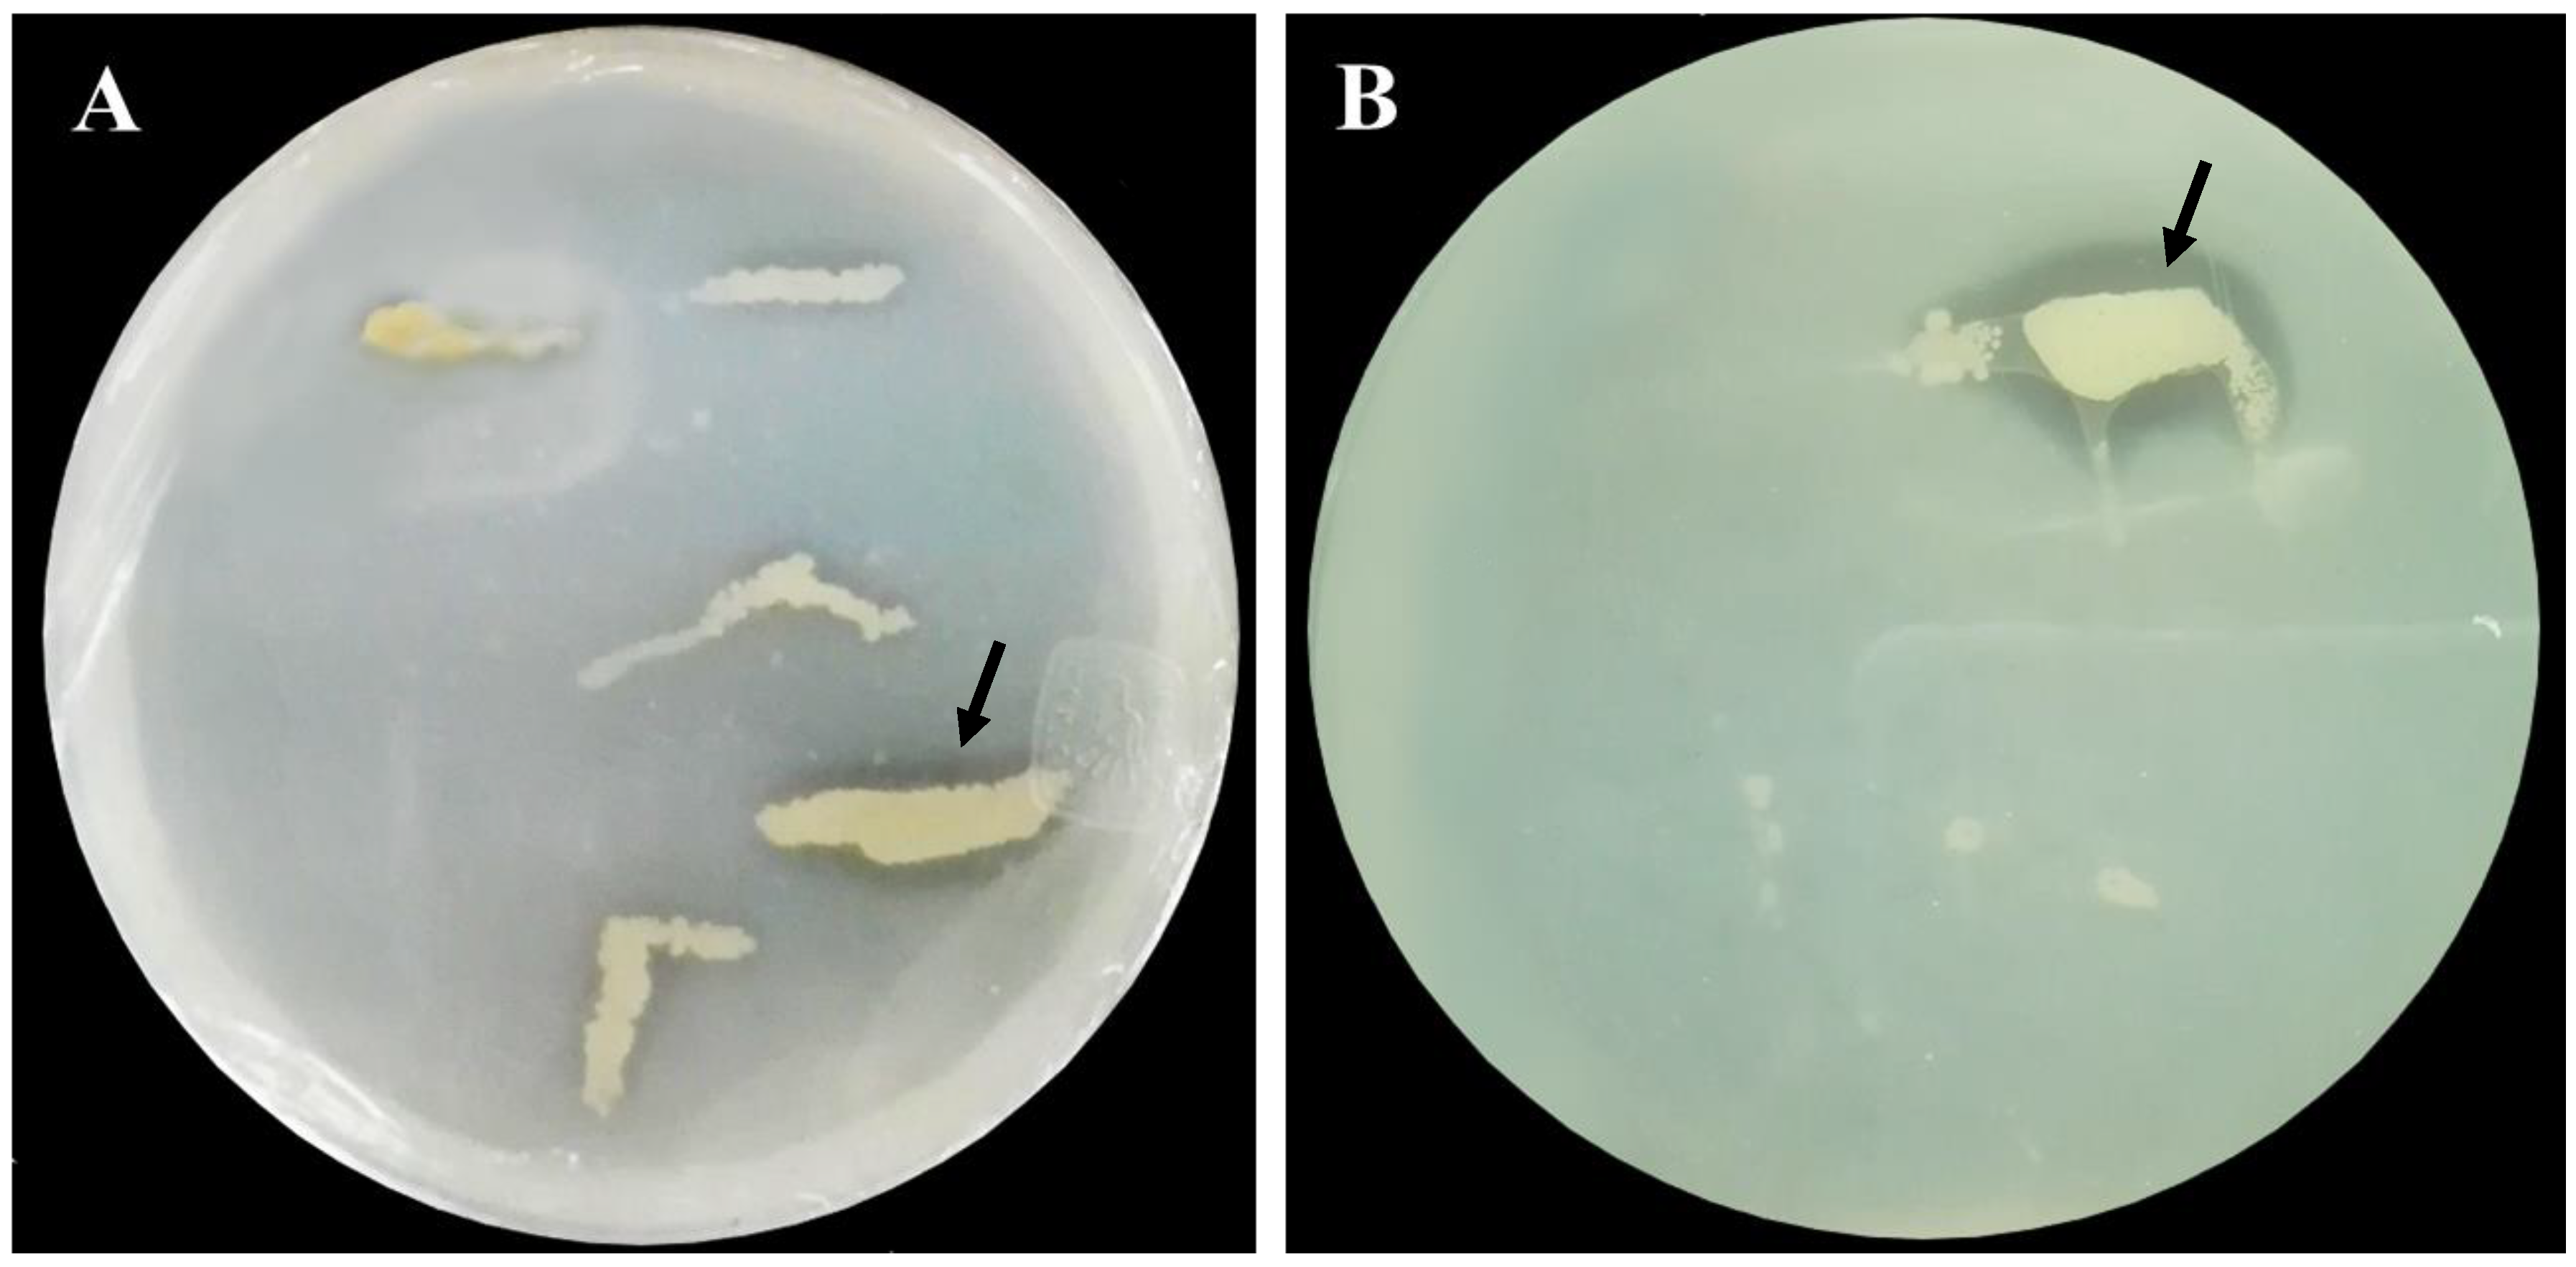
Horticulturae 10 00497 g001

Isolation and Identification of Lysinibacillus sp. and Its Effects on Solid Waste as a Phytate-Mineralizing Bacterium in an Aquaponics System
Abstract
1. Introduction
2. Materials and Methods
2.1. Isolation and Identification of Phytate-Mineralizing Bacteria
2.2. Taxonomic Classification of Bacteria at the Molecular Level
2.3. Test for the Biochemical Identification of Phytase-Producing Bacteria
2.4. In Vitro Mineralization Test on Solid Waste Generated from Aquaponic Systems
2.5. Determination of the Phytate and Nutrients Present in the Solid Waste
2.6. Determination of the Nutrient Release during the Mineralization of the Solid Waste
2.7. Statistical Analysis
3. Results
3.1. Isolation and Identification of Phytate-Mineralizing Bacteria
3.2. Phytate Mineralization and Phosphate Release from Sedimentary Solid Waste
3.3. Effect of L. mangiferihumi on the Mineralization and Release of Macro- and Micronutrients
4. Discussion
4.1. Isolation and Identification of Phytate-Mineralizing Bacteria
4.2. Phytate Mineralization in Sedimentary Solid Waste from Aquaponic Systems and Their Effect on Phosphorus Solubilization
4.3. Effect of L. mangiferihumi on the Release of Macro- and Micronutrients during the Mineralization Process
5. Conclusions
Supplementary Materials
Author Contributions
Funding
Data Availability Statement
Acknowledgments
Conflicts of Interest
References
- Goddek, S.; Joyce, A.; Kotzen, B.; Burnell, G. Aquaponics Food Production Systems; Springer Open: London, UK, 2019. [Google Scholar] [CrossRef]
- Masabni, J.; Niu, G. Chapter 10: Aquaponics. In Plant Factory Basics, Applications and Advances, 1st ed.; Kozai, T., Niu, G., Masabni, J., Eds.; Acadamic Press: Cambridge, MA, USA, 2022. [Google Scholar] [CrossRef]
- Goddek, S.; Delaide, B.; Mankasingh, U.; Ragnarsdottir, K.V.; Jijakli, H.; Thorarinsdottir, R. Challenges of Sustainable and Commercial Aquaponics. Sustainability 2015, 7, 4199–4224. [Google Scholar] [CrossRef]
- Goddek, S.; Delaide, B.P.; Joyce, A.; Wuertz, S.; Jijakli, M.H.; Gross, A.; Eding, E.H.; Bläser, I.; Reuter, M.; Keizer, L.P.; et al. Nutrient mineralization and organic matter reduction performance of RAS-based sludge in sequential UASB-EGSB reactors. Aquac. Eng. 2018, 83, 10–19. [Google Scholar] [CrossRef]
- Paneque, V.; Calaña, J.; Calderón, M.; Borges, Y.; Hernández, T.; Caruncho, M. Manual de Técnicas Analíticas para Análisis de Suelo, Foliar, Abonos Orgánicos y Fertilizantes Químicos, 1st ed.; Instituto Nacional de Ciencias Agrícolas, Departamento de Biofertilizantes y Nutrición de las Plantas, INCA: La Habana, Cuba, 2010. [Google Scholar]
- Cao, L.; Wang, W.; Yang, C.; Yang, Y.; Diana, J.; Yakupitiyage, A.; Luo, Z.; Li, D. Application of microbial phytase in fish feed. Enzym. Microb. Technol. 2007, 40, 497–507. [Google Scholar] [CrossRef]
- Tyson, R.V.; Simonne, E.H.; Treadwell, D.D.; White, J.M.; Simonne, A. Reconciling pH for Ammonia Biofiltration and Cucumber Yield in a Recirculating Aquaponic System with Perlite Biofilters. HortScience 2007, 43, 719–724. [Google Scholar] [CrossRef]
- da Silva Cerozi, B.; Fitzsimmons, K. Use of Bacillus spp. to enhance phosphorus availability and serve as a plant growth promoter in aquaponics systems. Sci. Hortic. 2016, 211, 277–282. [Google Scholar] [CrossRef]
- Makkar, H.P.S.; Perumal, S.; Becker, C. Plant Secondary Metabolites. In Methods in Molecular Biology, 1st ed.; Humana Press: Totowa, NJ, USA, 2007; ISBN 978-1588299932. [Google Scholar]
- Singh, P.; Kumar, V.; Agrawal, S. Evaluation of Phytase Producing Bacteria for Their Plant Growth Promoting Activities. Int. J. Microbiol. 2014, 2014, 426483. [Google Scholar] [CrossRef] [PubMed]
- Lazzari, R.; Baldisserotto, B. Nitrogen and Phosphorus Waste in Fish Farming. Bol. Do Inst. De Pesca 2008, 34, 591–600. [Google Scholar]
- Dunlap, C. Lysinibacillus mangiferihumi, Lysinibacillus tebacifolii and Lysinibacillus Variants are Later Heterotypic Synonyms of Lysinibacillus sphaericus. Int. J. Syst. Evol. Microbiol. 2019, 69, 2958–2962. [Google Scholar] [CrossRef] [PubMed]
- Jorquera, M.A.; Hernández, M.T.; Rengel, Z.; Marschner, P.; Mora, M.d.l.L. Isolation of culturable phosphobacteria with both phytate-mineralization and phosphate-solubilization activity from the rhizosphere of plants grown in a volcanic soil. Biol. Fertil. Soils 2008, 44, 1025–1034. [Google Scholar] [CrossRef]
- Mittal, A.; Singh, G.; Goyal, V.; Yadav, A.; Kumar, N. Production of phytase by acid-thermophilic strain of Klebsiella sp. DB-3FJ711774 using orange peel flour under submerged fermentation. Innov. Rom. Food Biotechnol. 2012, 10, 18–27. [Google Scholar]
- Maitra, N.; Whitman, W.; Ayyampalayam, S.; Samanta, S.; Sarkar, K.; Bandopadhyay, C.; Aftabuddin, M.; Sharma, A.; Manna, S. Draft genome sequence of the aquatic phosphorus solubilizing and mineralizing Bacterium Bacillus sp. Strain CPSM8. Genome Announc. 2014, 2, e01265-13. [Google Scholar] [CrossRef] [PubMed]
- Maitra, N.; Manna, S.K.; Samanta, S.; Sarkar, K.; Debnath, D.; Bandopadhyay, C.; Sahu, S.K.; Sharma, A.P. Ecological significance and phosphorus release potential of phosphate solubilizing bacteria in freshwater ecosystems. Hydrobiologia 2015, 745, 69–83. [Google Scholar] [CrossRef]
- Goddek, S.; Schmautz, Z.; Scott, B.; Delaide, B.; Keesman, K.J.; Wuertz, S.; Junge, R. The Effect of Anaerobic and Aerobic Fish Sludge Supernatant on Hydroponic Lettuce. Agronomy 2016, 6, 37. [Google Scholar] [CrossRef]
- Wilson, I.G. Inhibition and facilitation of nucleic acid amplification. Appl. Environ. Microbiol. 1997, 63, 3741–3751. [Google Scholar] [CrossRef]
- Barghouthi, S.A. A universal method for the identification of bacteria based on general PCR primers. Indian J. Microbiol. 2011, 51, 430–444. [Google Scholar] [CrossRef]
- Kerovuo, J.A. Novel Phytase from Bacillus Characterization and Production of the Enzyme. Master’s Thesis, University of Helsinki, Helsinki, Finland, 2000. [Google Scholar]
- Jamal, Q.M.S.; Ahmad, V. Lysinibacilli: A Biological Factories Intended for Bio-Insecticidal, Bio-Control, and Bioremediation Activities. J. Fungi 2022, 8, 1288. [Google Scholar] [CrossRef] [PubMed]
- Demirkan, E.; Baygin, E.; Usta, A. Screening of Phytate Hydrolysis Bacillus sp. Isolated from Soil and Optimization of the Certain Nutritional and Physical Parameters on the Production of Phytase. Turk. J. Biochem. 2014, 39, 206–214. [Google Scholar] [CrossRef]
- Wheeler, E.L.; and Ferrel, R.E. A method for phytic acid determination in wheat and wheat fractions. Cereal Chem. 1997, 48, 312–320. [Google Scholar]
- Rodríguez, H.; Rodríguez, J. Métodos de Análisis de Suelos y Plantas, 1st ed.; Trillas, S.A., Ed.; de CV: Mexico City, Mexico, 2013; ISBN 978-607-17-0593-8. [Google Scholar]
- Balaban, N.P.; Suleimanova, A.D.; Valeeva, L.R.; Chastukhina, I.B.; Rudakova, N.L.; Sharipova, M.R.; Shakirov, E.V. Microbial Phytases and Phytate: Exploring Opportunities for Sustainable Phosphorus Management in Agriculture. Am. J. Mol. Biol. 2017, 7, 11–29. [Google Scholar] [CrossRef]
- Slepecky, R.A.; Ernest, H. The Genus Bacillus-Nonmedical. In The Prokaryotes; Edward, F., Delong, S., Erko, S., Thompson, F., Eds.; Springer: New York, NY, USA, 2006. [Google Scholar] [CrossRef]
- Schmautz, Z.; Graber, A.; Jaenicke, S.; Goesmann, A.; Junge, R.; Smits, T.H.M. Microbial diversity in different compartments of an aquaponics system. Arch. Microbiol. 2017, 199, 613–620. [Google Scholar] [CrossRef]
- Anis Shobirin, M.H.; Farouk, A.; Greiner, R. Potential Phytate-degrading Enzyme Producing Bacteria Isolated from Malaysian Maize Plantation. J. Biotechnol. 2009, 8, 3540–3546. [Google Scholar]
- Gulati, H.K.; Chadha, B.S.; Saini, H.S. Production and characterization of thermostable alkaline phytase from Bacillus laevolacticus isolated from rhizosphere soil. J. Ind. Microbiol. Biotechnol. 2007, 34, 91–98. [Google Scholar] [CrossRef] [PubMed]
- Jain, U.; Chauhan, N. Bacillus cereus Phytase-Detection, Purification, Characterization and Physiological Role. Int. J. Sci. Res. Dev. 2014, 2, 14–19. [Google Scholar]
- Joseph, I.; Raj, R.P. Isolation and Characterization of Phytase Producing Bacillus Strains from Mangrove Ecosystem. J. Mar. Biol. Assoc. India 2007, 49, 177–182. [Google Scholar]
- Oh, B.-C.; Choi, W.-C.; Park, S.; Kim, Y.-O.; Oh, T.-K. Biochemical properties and substrate specificities of alkaline and histidine acid phytases. Appl. Microbiol. Biotechnol. 2004, 63, 362–372. [Google Scholar] [CrossRef] [PubMed]
- Olajuyigbe, F.M. Optimization of extracellular phytase production from Bacillus amyloliquefaciens PFB-02 Grown on Selected Agricultural Waste. Appl. Trop. Agric. 2016, 5, 92–97. [Google Scholar]
- Ramani, V. Organic Phosphate Mineralization by Bacillus sphaericus and Pseudomonas cepacia. Int. J. Agric. Technol. 2014, 10, 915–922. [Google Scholar]
- Madigan, M.; Martinko, J.; Parker, J. Biología de los Microorganismos, 14th ed.; Pearson: Madrid, Spain, 2010; ISBN 9788490352793. [Google Scholar]
- Schneider, O.; Sereti, V.; Eding, E.; Verreth, J. Analysis of nutrient flows in integrated intensive aquaculture systems. Aquac. Eng. 2005, 32, 379–401. [Google Scholar] [CrossRef]
- Monsees, H.; Keitel, J.; Paul, M.; Kloas, W.; Wuertz, S. Potential of aquacultural sludge treatment for aquaponics: Evaluation of nutrient mobilization under aerobic and anaerobic conditions. Aquac. Environ. Interact. 2017, 9, 9–18. [Google Scholar] [CrossRef]
- Beristain, B. Organic Matter Decomposition in Simulated Aquaculture Ponds; Wageningen Universiteit: Wageningen, The Netherlands, 2005. [Google Scholar]
- Henao, C.B.; Rincón, S.C. Aislamiento y Producción de Bacterias Fosfato Solubilizadoras a Partir de Compost. Bachelor’s Thesis, Universidad Javeriana, Bogotá, Colombia, 2008. [Google Scholar]
- Hua, K.; Bureau, D.P. Modeling Digestible Phosphorus Content of Salmonid Fish Feeds. Aquaculture 2006, 254, 455–465. [Google Scholar] [CrossRef]
- Dillow, R.K. International Institute for Sustainable Development (IISD). In Encyclopedia of Global Warming and Climate Change; Philander, S., Ed.; Sage Publications: Sauzendaux, CA, USA, 2008. [Google Scholar] [CrossRef]
- Balogun, S.; Gbadebo, A.; Sharaf, O.; Hareem, A.S. Cadmium Uptake by Biomass of Lysinibacillus sphaericus KY203810 and Enterobacter cloacae KY203811 from Steel Company Dumpsite. Pac. J. Sci. Technol. 2017, 18, 265–276. [Google Scholar]
- Naureen, Z.; Rehman, N.; Hussain, H.; Hussain, J.; Gilani, S.; Housni, S.; Mabood, F.; Khan, A.; Farooq, S.; Abbas, G.; et al. Exploring the Potentials of Lysinibacillus sphaericus ZA9 for Plant Growth Promotion and Biocontrol Activities Against Phytopathogenic Fungi. Front. Microbiol. 2017, 8, 1477. [Google Scholar] [CrossRef] [PubMed]
- Rafique, M.; Sultan, T.; Ortas, I.; Chaudhary, H.J. Enhancement of maize plant growth with inoculation of phosphate-solubilizing bacteria and biochar amendment in soil. Soil Sci. Plant Nutr. 2017, 63, 460–469. [Google Scholar] [CrossRef]
- Yang, L.-L.; Huang, Y.; Liu, J.; Ma, L.; Mo, M.-H.; Li, W.-J.; Yang, F.-X. Lysinibacillus mangiferahumi sp. nov., a new bacterium producing nematicidal volatiles. Antonie Van Leeuwenhoek 2012, 102, 53–59. [Google Scholar] [CrossRef] [PubMed]
- Vásquez, W. Principios de Nutrición Aplicada al Cultivo de Peces, 1st ed.; Editorial Juan XVIII Ltda: Los Llanos, Colombia, 2004. [Google Scholar]
- Castellanos, J. (Ed.) Manual de Producción de Tomate en Invernadero, 1st ed.; Intagri S.C: Celaya, México, 2009; p. 456. [Google Scholar]
- Delaide, B. A Study on the Mineral Elements Available in Aquaponics, Their Impact on Lettuce Productivity and the Potential Improvement of Their Availability; Université de Liège-Gembloux Agrio Biotech: Gembloux, Belgium, 2017. [Google Scholar]
- Rafiee, G.; Saad, C.R. Nutrient cycle and sludge production during different stages of red tilapia (Oreochromis sp.) growth in a recirculating aquaculture system. Aquaculture 2005, 244, 109–118. [Google Scholar] [CrossRef]
- Barker, A.; Pillbeam, D. Handbook of Plant Nutrition; Taylor & Francis: London, UK, 2006. [Google Scholar]
- Krachler, R.F.; Krachler, R.; Stojanovic, A.; Wielander, B.; Herzig, A. Effects of pH on Aquatic Biodegradation Processes. Biogeosciences Discuss. 2009, 6, 491–514. [Google Scholar] [CrossRef]
- Mc Cauley, A.; Clain, J.; Olson-Rutz, K. Soil pH and Organic Matter. J. Mont. State Univ. 2017, 8, 1–12. [Google Scholar]
- Li, C.; Zhang, B.; Luo, P.; Shi, H.; Li, L.; Gao, Y.; Lee, C.T.; Zhang, Z.; Wu, W.-M. Performance of a pilot-scale aquaponics system using hydroponics and immobilized biofilm treatment for water quality control. J. Clean. Prod. 2019, 208, 274–284. [Google Scholar] [CrossRef]
- Bartelme, R.P.; Oyserman, B.O.; Bloom, J.E.; Sepulveda-Villet, O.J.; Newton, R.J. Stripping Away the Soil: Plant Growth Promoting Microbiology Opportunities in Aquaponics. Front. Microbiol. 2018, 9, 8. [Google Scholar] [CrossRef]
- Piñero, M.C.; Collado-González, J.; Otálora, G.; López-Marín, J.; del Amor, F.M. Plant Growth Promoting Bacteria for Aquaponics as a New Strategy That Grants Quality and Nutrient Efficiency in Kohlrabi Cultivation. Horticulturae 2023, 9, 1299. [Google Scholar] [CrossRef]
- Mangmang, J.S.; Deaker, R.; Rogers, G. Inoculation effect of Azospirillum brasilense on basil grown under aquaponics production system. Org. Agric. 2016, 6, 65–74. [Google Scholar] [CrossRef]
- Sirakov, I.; Lutz, M.; Graber, A.; Mathis, A.; Staykov, Y.; Smits, T.H.M.; Junge, R. Potential for Combined Biocontrol Activity against Fungal Fish and Plant Pathogens by Bacterial Isolates from a Model Aquaponic System. Water 2016, 8, 518. [Google Scholar] [CrossRef]
- Khastini, R.; Idaryanto, F.R.; Alimuddin; Wahyuni, I.; Sari, I.J.; Puspita, N.; Wahyuni, A.F. Microbial consortia effects on the yields of water spinach in milkfish aquaponics system. IOP Conf. Ser. Earth Environ. Sci. 2019, 383, 012040. [Google Scholar] [CrossRef]
- Mohamed, M.S.; Zaki, F.M.; Ahmedn, O.M. Effect of the Probiotic (Bacillus spp.) on Water Quality, Production Performance, Microbial Profile, and Flood Safety of the Nile Tilapia and Mint in Recirculating Aquaponic System. Egypt. J. Aquat. Biol. Fish. 2022, 26, 351–372. [Google Scholar]
- Rivas-García, T.; González-Estrada, R.R.; Chiquito-Contreras, R.G.; Reyes-Pérez, J.J.; González-Salas, U.; Hernández-Montiel, L.G.; Murillo-Amador, B. Biocontrol of Phytopathogens under Aquaponics Systems. Water 2020, 12, 2061. [Google Scholar] [CrossRef]

| Inoculation | Temp. | Oxygen | K | S | Ca | Total P | P (PO4−) | Mg |
|---|---|---|---|---|---|---|---|---|
| Strain | °C | rpm | mg L−1 | |||||
| Control | 24 | 0 | 189.5 ± 52.1 a | 306.2 ± 20.7 de | 90.9 ± 6.9 e | 262.8 ± 3.5 cd | 7.3 ± 1.4 fg | 25.9 ± 0.9 c |
| 200 | 114.6 ± 42.2 e | 470.4 ± 9.4 a | 200.0 ± 3.4 d | 73.6 ± 32.2 f | 18.3 ± 1.4 c | 30.9 ± 0.9 a | ||
| 37 | 0 | 139.7 ± 52.7 b | 359.7 ± 17.6 bc | 55.0 ± 3.6 f | 82.9 ± 9.8 f | 6.4 ± 0.6 g | 22.5 ± 0.1 d | |
| 200 | 86.6 ± 30.2 e | 329.1 ± 18.2 cde | 55.0 ± 3.2 f | 72.2 ± 10.3 f | 16.8 ± 0.4 cd | 22.3 ± 1.8 d | ||
| Sp-5 | 24 | 0 | 147.1 ± 41.7 bcd | 296.6 ± 3.7 cde | 41.7 ± 3.8 fg | 320.9 ± 71.1 cd | 7.3 ± 2.5 g | 22.7 ± 2.0 d |
| 200 | 122.3 ± 3.79 bcd | 465.9 ± 8.1 a | 301.9 ± 8.1 a | 534.1 ± 6.0 de | 15.0 ± 4.8 d | 31.7 ± 1.1 a | ||
| 37 | 0 | 149.9 ± 31.2 bc | 329.2 ± 11.7 ef | 39.5 ± 11.7 gh | 149.3 ± 29.5 ef | 9.8 ± 1.3 ef | 19.5 ± 0.6 e | |
| 200 | 102.4 ± 5.5 cde | 364.6 ± 4.8 bc | 277.7 ± 4.8 b | 872.9 ± 114.5 b | 27.8 ± 2.7 b | 28.7 ± 0.1 b | ||
| Sp-6 | 24 | 0 | 125.2 ± 2.4 bcd | 269.0 ± 5.8 q | 33.5 ± 5.8 gh | 356.3 ± 39.2 cd | 10.9 ± 1.3 e | 23 ± 1.0 d |
| 200 | 124.9 ± 6.4 bcd | 473.0 ± 4.5 a | 302.8 ± 4.5 a | 1193.9 ± 70.7 a | 33.4 ± 1.6 a | 31.9 ± 0.8 a | ||
| 37 | 0 | 141.5 ± 4.1 b | 303.0 ± 1.2 f | 31.3 ± 1.2 h | 143.9 ± 19.9 ef | 8.1 ± 1.0 g | 19.0 ± 1.0 e | |
| 200 | 92.1 ± 14.6 de | 323.0 ± 34.8 bcd | 238.3 ± 34.8 c | 638.9 ± 1.0 b | 27.01 ± 1.0 b | 26.1 ± 2.8 b | ||
| ANOVA | *** | *** | *** | *** | *** | *** | ||
| Temp × Oxygen | NS | * | NS | NS | NS | NS | ||
| Temp × Inoculation | NS | NS | * | *** | *** | * | ||
| Oxygen × Inoculation | * | NS | *** | *** | *** | *** | ||
| Temp × Oxygen × Inoculation | NS | * | ** | *** | *** | ** | ||
| Inoculation | Temp. | Oxygen | Fe | Zn | Cu | Mn | Mo |
|---|---|---|---|---|---|---|---|
| Strain | °C | rpm | mg L−1 | ||||
| Control | 24 | 0 | 0.9 ± 0.3 a | 0.7 ± 0.1 | ND | ND | 0.1 ± 0.9 |
| 200 | 0.7 ± 0.1 abc | 1.0 ± 0.2 | 0.03 ± 0.01 | ND | 0.2 ± 0.2 | ||
| 37 | 0 | 0.3 ± 0.1 de | 0.8 ± 0.01 | ND | ND | 0.3 ± 0.03 | |
| 200 | 0.1 ± 0.1 e | 0.6 ± 0.02 | 0.02 ± 0.03 | ND | 0.5 ± 0.2 | ||
| Sp-5 | 24 | 0 | 0.4 ± 0.06 cde | 0.6 ± 0.01 | ND | ND | ND |
| 200 | 1.0 ± 0.05 a | 0.8 ± 0.3 | 0.04 ± 0.02 | 0.3 ± 0.2 | 0.6 ± 0.4 | ||
| 37 | 0 | 0.9 ± 0.08 ab | 0.3 ± 0.2 | 0.06 ± 0.02 | ND | 0.2 ± 0.1 | |
| 200 | 1.0 ± 0.1 a | 0.9 ± 0.4 | 0.02 ± 0.05 | 0.4 ± 0.02 | 0.3 ± 0.2 | ||
| Sp-6 | 24 | 0 | 0.4 ± 0.07 bcde | 0.7 ± 0.09 | 0.05 ± 0.09 | ND | 0.2 ± 0.3 |
| 200 | 0.9 ± 0.2 a | 0.5 ± 0.05 | 0.04 ± 0.07 | 0.4 ± 0.06 | 0.2 ± 0.3 | ||
| 37 | 0 | 0.3 ± 0.1 de | 0.8 ± 0.3 | 0.06 ± 0.03 | ND | 0.2 ± 0.02 | |
| 200 | 0.6 ± 0.03 abcd | 0.5 ± 0.1 | 0.02 ± 0.08 | 0.3 ± 0.1 | ND | ||
| ANOVA | * | NS | NS | NS | NS | ||
| Temp × Oxygen | NS | NS | NS | NS | NS | ||
| Temp × Inoculation | ** | NS | NS | NS | NS | ||
| Oxygen × Inoculation | * | NS | NS | NS | NS | ||
| Temp × Oxygen × Inoculation | NS | NS | NS | NS | NS | ||
Disclaimer/Publisher’s Note: The statements, opinions and data contained in all publications are solely those of the individual author(s) and contributor(s) and not of MDPI and/or the editor(s). MDPI and/or the editor(s) disclaim responsibility for any injury to people or property resulting from any ideas, methods, instructions or products referred to in the content. |
© 2024 by the authors. Licensee MDPI, Basel, Switzerland. This article is an open access article distributed under the terms and conditions of the Creative Commons Attribution (CC BY) license (https://creativecommons.org/licenses/by/4.0/).
Share and Cite
Riaño-Castillo, E.R.; Rodríguez-Ortiz, J.C.; Kim, H.-J.; Guerrero González, M.d.l.L.; Quintero-Castellanos, M.F.; Delgado-Sánchez, P. Isolation and Identification of Lysinibacillus sp. and Its Effects on Solid Waste as a Phytate-Mineralizing Bacterium in an Aquaponics System. Horticulturae 2024, 10, 497. https://doi.org/10.3390/horticulturae10050497
Riaño-Castillo ER, Rodríguez-Ortiz JC, Kim H-J, Guerrero González MdlL, Quintero-Castellanos MF, Delgado-Sánchez P. Isolation and Identification of Lysinibacillus sp. and Its Effects on Solid Waste as a Phytate-Mineralizing Bacterium in an Aquaponics System. Horticulturae. 2024; 10(5):497. https://doi.org/10.3390/horticulturae10050497
Chicago/Turabian StyleRiaño-Castillo, Edna Rocio, Juan Carlos Rodríguez-Ortiz, Hye-Ji Kim, María de la Luz Guerrero González, María Fernanda Quintero-Castellanos, and Pablo Delgado-Sánchez. 2024. "Isolation and Identification of Lysinibacillus sp. and Its Effects on Solid Waste as a Phytate-Mineralizing Bacterium in an Aquaponics System" Horticulturae 10, no. 5: 497. https://doi.org/10.3390/horticulturae10050497
APA StyleRiaño-Castillo, E. R., Rodríguez-Ortiz, J. C., Kim, H.-J., Guerrero González, M. d. l. L., Quintero-Castellanos, M. F., & Delgado-Sánchez, P. (2024). Isolation and Identification of Lysinibacillus sp. and Its Effects on Solid Waste as a Phytate-Mineralizing Bacterium in an Aquaponics System. Horticulturae, 10(5), 497. https://doi.org/10.3390/horticulturae10050497

